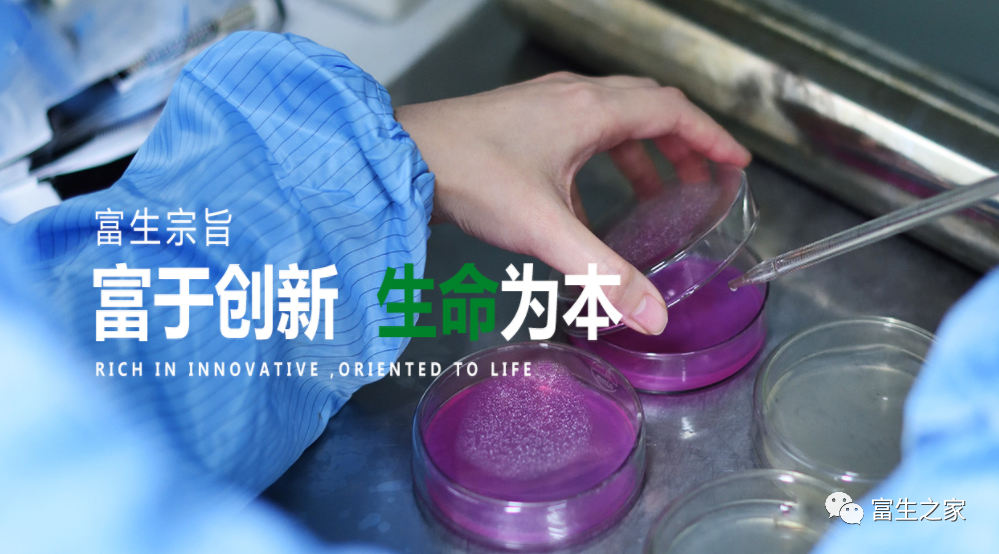
1587715361876843.png image.png

富生醫(yī)療FUSHENGYILIAO
公司大事記MORE+
聯(lián)系我們CONTACT US
地址:長春雙陽經(jīng)濟(jì)開發(fā)區(qū)康悅路18號
電話:0431-85858205 0431-85858206
新聞動態(tài)
您當(dāng)前的位置:新聞動態(tài)
有獎?wù)魑模宏P(guān)于透析及腎健康疑難問題的征集
作者:佚名 | 來源:采集 | 時間:2020-04-24
一、活動主旨
富于創(chuàng)新 生命為本
二、征集對象
透析患者及家屬、醫(yī)護(hù)人員
三、征集時間
即日起至5月10日
四、征集要求
1.所有公眾號留言或者郵箱發(fā)送,必須附作者姓名(如果不想公布可以寫代稱)、聯(lián)系電話,具體地址(寫明城市、小區(qū)門牌號,方便獲獎后郵寄獎品);
2.每人提交問題數(shù)量不限,力求精練。
五、征集方式
1.關(guān)注“富生之家”公眾號,將透析、腎健康問題在公眾號留言;
2.接收郵箱:jilinfusheng_hr@163.com,郵件主題注明:富生之家問題征集投稿+作者。投稿電話:0431-81102277、18043613809。
六、作品發(fā)布
七、活動獎勵
1.提交腎健康領(lǐng)域問題的符合要求的投稿作品者,獎勵富生集團(tuán)提供價值18元的免洗手消毒液一瓶(100Ml),包郵到家;
2. 連續(xù)三天轉(zhuǎn)發(fā)此篇征集活動文章并集88個贊(三天任意一天單次積攢88個贊即可,不可三日累計),將截圖與問題一并發(fā)送郵箱,另將獎勵富生集團(tuán)提供價值78元的餅干一盒。

歡迎投稿
歡迎各位患者、家屬及醫(yī)護(hù)人員積極參與,毫無保留的提出透析、腎健康相關(guān)問題、我們會全力為您解答。
富生腎友交流群 群主微信號:xy18043613803




